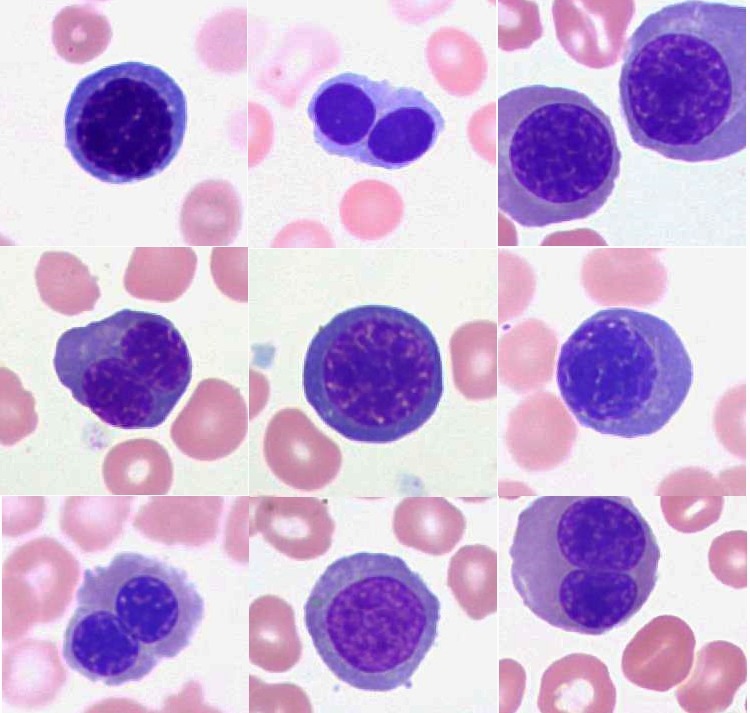

Появление бласта
Until death do us part
Nfs file system
Какой оквэд для тендеров
Результат краснодар химки
Entry в питоне
Алекс твин
Название документа сущность декрет о мире таблица
Завести сервала
Моя удмуртия ижевск сегодня
Любила его отца да и
Панель приборов 21093
Автосалоны омск б у
Подшипник рулевой рейки форд фокус 3
Появление бласта 111 фото